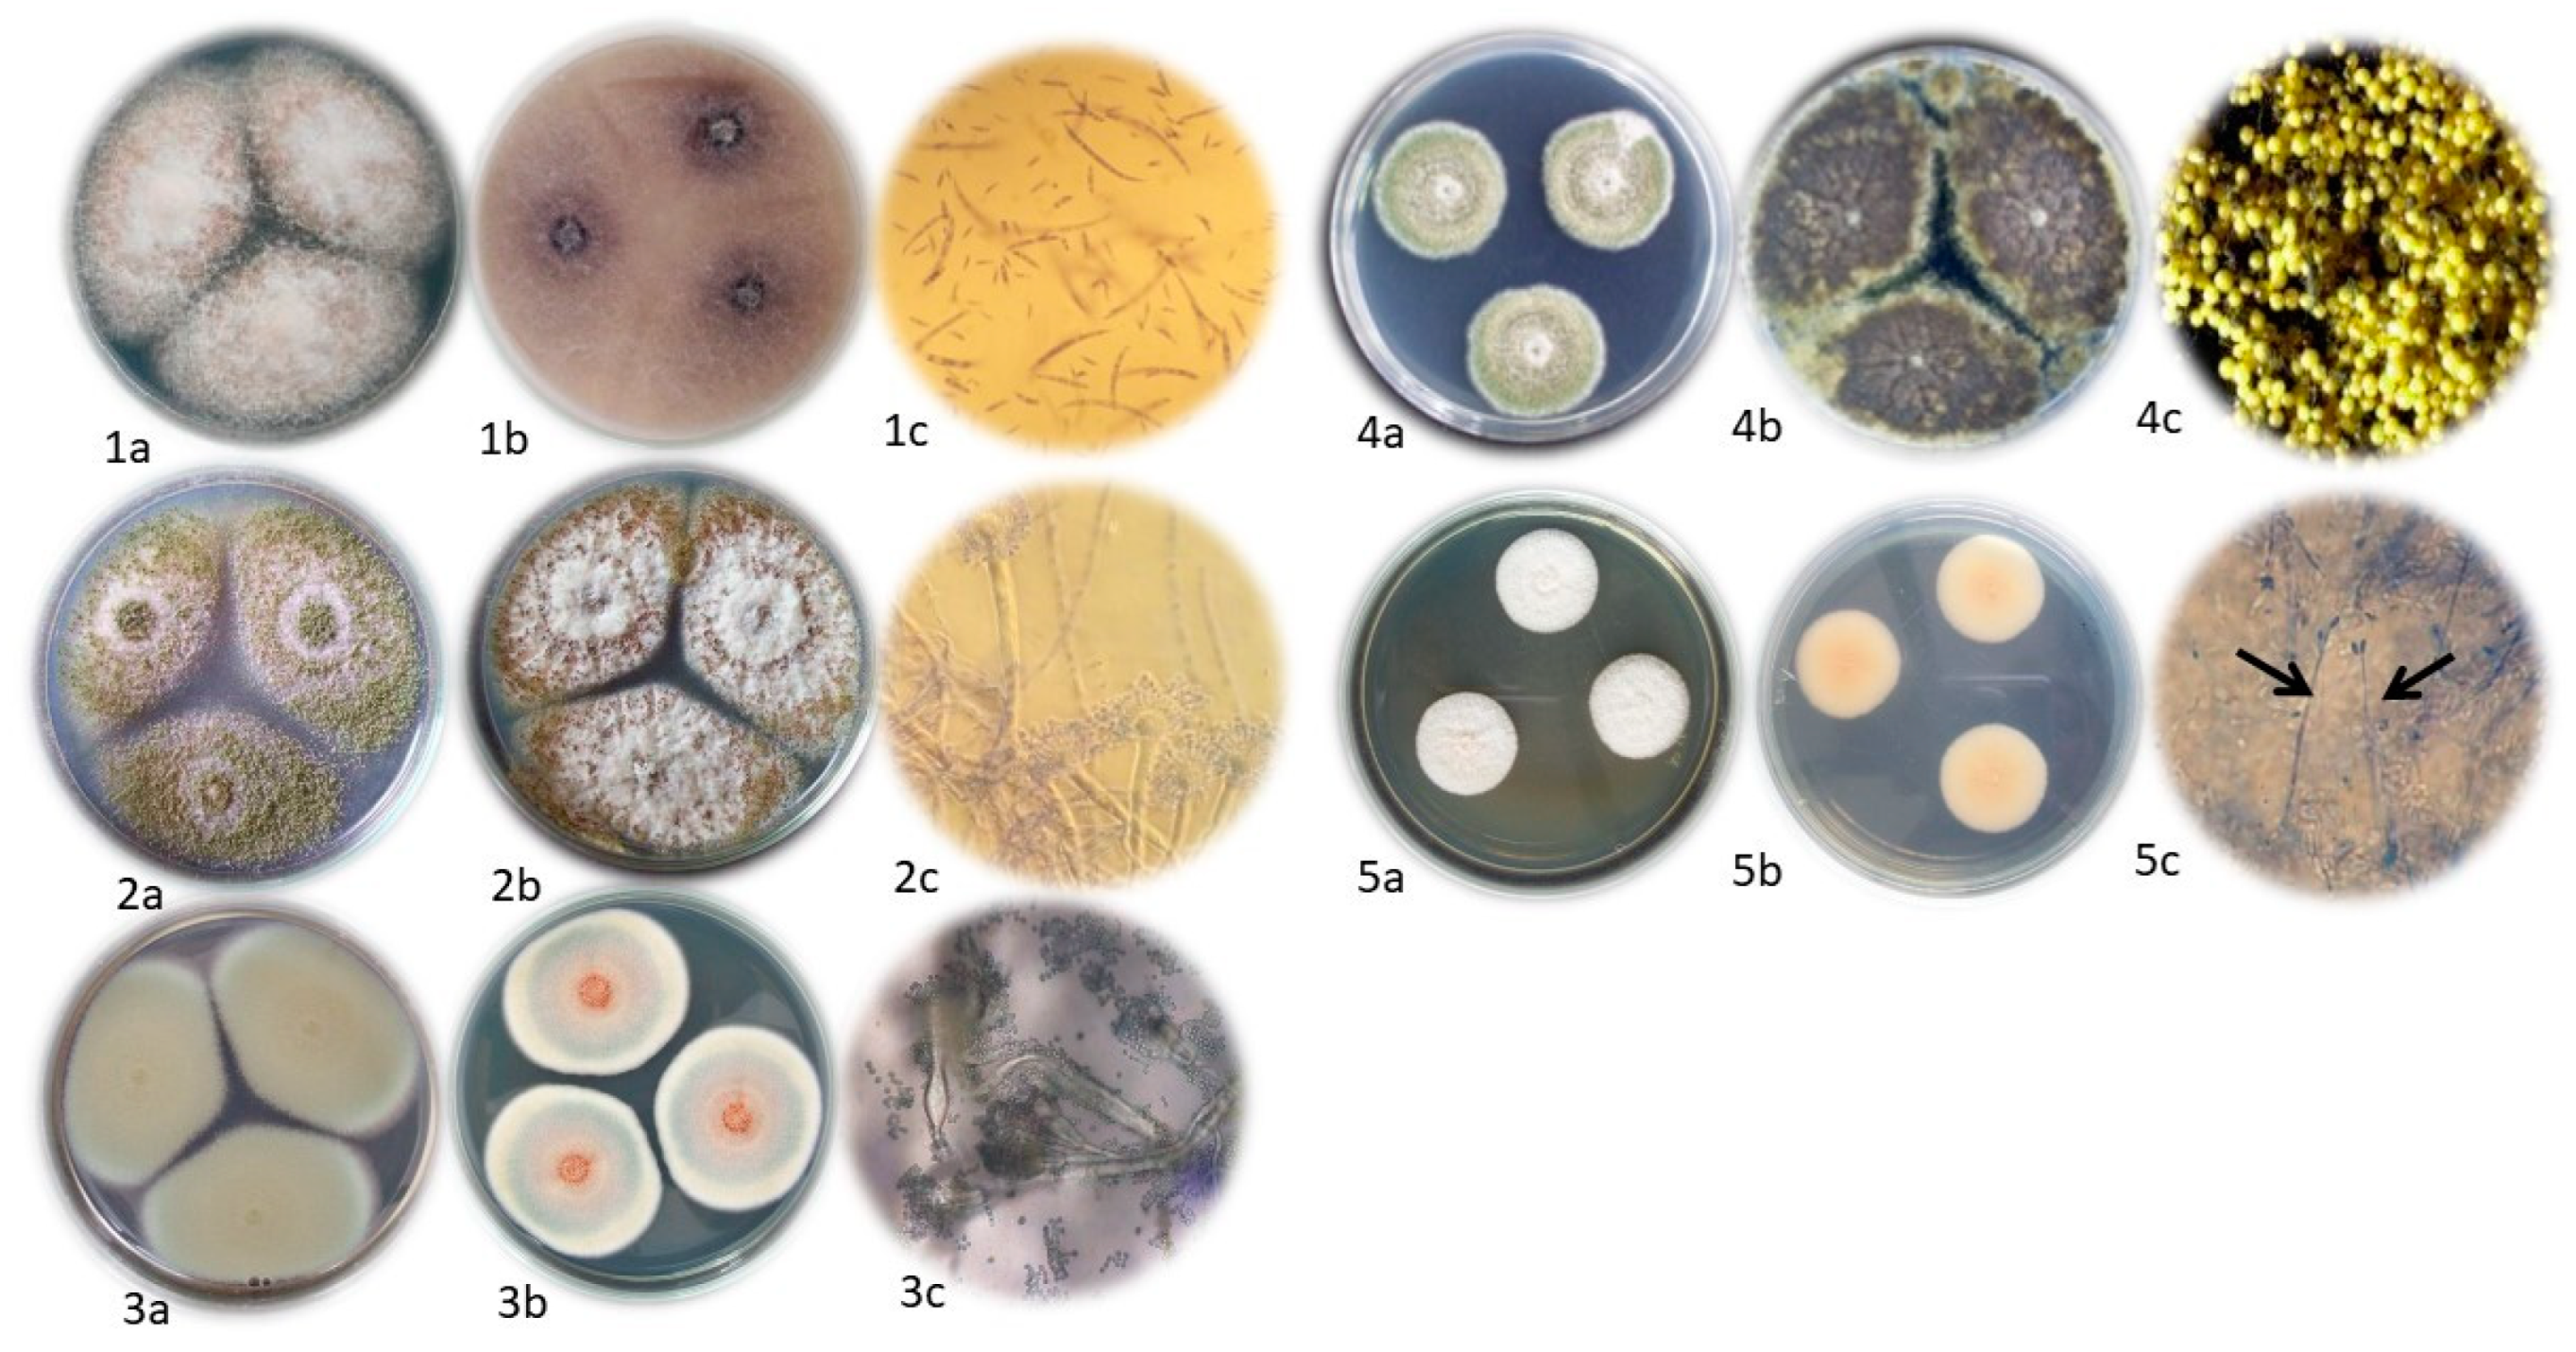

Fungal Biota and Mycotoxins Contamination in Soybean Expeller
Abstract
1. Introduction
2. Materials and Methods
2.1. Sampling of Soybean Expeller
2.2. Moisture Content Measurement
2.3. Quantification and Identification Methods of Fungal Biota
2.4. Mycotoxins Analysis
2.5. Statistical Analysis
3. Results
3.1. Quantification and Identification of Fungal Biota
3.2. Relationship Between Soybean Expeller Moisture Content and Fungal Biota Load
3.3. Detection and Quantification of Mycotoxins
4. Discussion
4.1. Implications of Fungal Biota Quantification and Identification
4.2. Implications of Soybean Expeller Moisture Content on Fungal Biota Load
4.3. Assessment of Mycotoxins Contamination and Its Implications in Soybean Expeller
5. Conclusions
Author Contributions
Funding
Data Availability Statement
Acknowledgments
Conflicts of Interest
Abbreviations
| SBE | Soybean expeller |
| MC | Moisture content |
| CFU | Colony forming unit |
| DON | Deoxynivalenol |
| AF | Aflatoxin |
| d.b. | Dry basis |
| w.b. | Wet basis |
| DM | Dry matter |
| PDA | Potato dextrose agar |
| LOD | Limit of detection |
| LOQ | Limit of quantification |
| ANOVA | Analysis of variance |
| SD | Standard deviation |
| GMP | Good Manufacturing Practices |
Appendix A
| Analyte Name | Ionization | Precursor Ion (m/z) | Ion Species | Product Ion (m/z) | Collision Cell | |
|---|---|---|---|---|---|---|
| Ion Q | Ion C | |||||
| DON | ESI+ | 297 | [M+H]+ | 249 | 231 | 39 |
| Nivalenol | ESI- | 311 | [M−H]− | 183 | 281 | 39 |
| 13 acetil DON | ESI+ | 339 | [M+H]+ | 231 | 213 | 39 |
| 15 acetil DON | ESI+ | 339 | [M+H]+ | 321 | 137 | 39 |
| Nivalenol | ESI- | 371 | [M+OAc]− | 311 | 281 | 45 |
| AFB1 | ESI+ | 313 | [M+H]+ | 284 | 241 | 25 |
| AFB2 | ESI+ | 315 | [M+H]+ | 286 | 259 | 28 |
| AFG1 | ESI+ | 329 | [M+H]+ | 243 | 200 | 25 |
| AFG2 | ESI+ | 331 | [M+H]+ | 313 | 245 | 28 |
References
- Nelson, A.I.; Wijeratne, W.B.; Yeh, S.W.; Wei, T.M.; Wei, L.S. Dry Extrusion as an Aid to Mechanical Expelling of Oil from Soybeans. J. Am. Oil Chem. Soc. 1987, 64, 1341–1347. [Google Scholar] [CrossRef]
- Bargale, P.C.; Ford, R.J.; Sosulski, F.W.; Wulfsohn, D.; Irudayaraj, J. Mechanical Oil Expression from Extruded Soybean Samples. J. Am. Oil Chem. Soc. 1999, 76, 223–229. [Google Scholar]
- Bragachini, M.; Ustarroz, F.; Saavedra, A.E.; Méndez, J.M.; Mathier, D.; Bragachini, M.; Sosa, N.; Alladio, R.M.; Accoroni, C.; Hennung, H. Evolución Del Sistema Productivo Agropecuario Argentino; Manfredi: Córdoba, Argentina, 2017. [Google Scholar]
- Medic, J.; Atkinson, C.; Hurburgh, C.R. Current Knowledge in Soybean Composition. J. Am. Oil Chem. Soc. 2014, 91, 363–384. [Google Scholar] [CrossRef]
- Papier, K.; Tong, T.Y.; Appleby, P.N.; Bradbury, K.E.; Fensom, G.K.; Knuppel, A.; Perez-Cornago, A.; Schmidt, J.A.; Travis, R.C.; Key, T.J. Comparison of Major Protein-Source Foods and Other Food Groups in Meat-Eaters and Non-Meat-Eaters in the Epic-Oxford Cohort. Nutrients 2019, 11, 824. [Google Scholar] [CrossRef]
- SAGyP. Molienda de Granos Oleaginosos, Producción de Aceites, Pellets y Expellers. Available online: https://www.magyp.gob.ar/sitio/areas/ss_mercados_agropecuarios/areas/granos/_archivos/000058_Estad%C3%ADsticas/000032_Evolucion%20de%20la%20Molienda%20(Cereales%20y%20Oleaginosas)/000002_Evoluci%C3%B3n%20de%20la%20Molienda%20Mensual%20-%20Oleaginosas/000002_Evoluci%C3%B3n%20de%20la%20Molienda%20Mensual%20-%20Oleaginosas.php (accessed on 25 September 2024).
- RUCA-MAGyP. Registro Único de La Cadena Agroalimentaria. Available online: https://ruca.magyp.gob.ar/padron/ (accessed on 24 November 2023).
- Maciel, G.; Wagner, J.R.; Juan, N.A.; San Martino, S.; Bartosik, R.E. Assessment of the Main Sources of Variability of Soybean (Glycine Max) Expeller Composition and Quality: A Field Study. Agric. Eng. Int. CIGR J. 2020, 22, 211–220. [Google Scholar]
- Juan, N.A.; Massigogue, J.I.; Errasquin, L.; Méndez, J.M.; Ochandio, D.C.; Saavedra, A.E.; Paolilli, M.C.; Alladio, R.M.; Accoroni, C.; Behr, E.F. Calidad de la Soja Procesada y del Expeller Producido por la Industria de Extrusado-Prensado en Argentina; Ediciones INTA: Buenos Aires, Argentina, 2015. [Google Scholar]
- SAGPyA. Resolución SAGPyA N°317/99. Norma XIX: Subproductos de Oleaginosos; SAGPyA: Buenos Aires, Argentina, 1999; p. 10. [Google Scholar]
- Kumar, C.; Karim, M.A.; Joardder, M.U.H. Intermittent Drying of Food Products: A Critical Review. J. Food Eng. 2014, 121, 48–57. [Google Scholar] [CrossRef]
- Smith, J.E.; Solomons, G.; Lewis, C.; Anderson, J.G. Role of Mycotoxins in Human and Animal Nutrition and Health. Nat. Toxins 1995, 3, 187–192. [Google Scholar] [CrossRef]
- Barros, G.G.; Oviedo, M.S.; Ramirez, M.L.; Chulze, S.N. Safety Aspect in Soybean Food and Feed Chains: Fungal and Mycotoxins Contamination. In Soybean—Biochemistry, Chemistry and Psysiology; IntechOpen: London, UK, 2011; pp. 7–20. [Google Scholar]
- Fleurat-Lessard, F. Integrated Management of the Risks of Stored Grain Spoilage by Seedborne Fungi and Contamination by Storage Mould Mycotoxins—An Update. J. Stored Prod. Res. 2017, 71, 22–40. [Google Scholar] [CrossRef]
- Magan, N.; Sanchis, V.; Aldred, D. The Role of Spoilage Fungi in Seed Deterioration. In Fungal Biotechnology in Agricultural, Food and Environmental Applications; CRC Press: Boca Raton, FL, USA, 2004; Chapter 28; pp. 311–323. [Google Scholar]
- Sirohi, R.; Tarafdar, A.; Kumar Gaur, V.; Singh, S.; Sindhu, R.; Rajasekharan, R.; Madhavan, A.; Binod, P.; Kumar, S.; Pandey, A. Technologies for Disinfection of Food Grains: Advances and Way Forward. Food Res. Int. 2021, 145, 110396. [Google Scholar] [CrossRef]
- Suleiman, R.A.; Rosentrater, K.A.; Bern, C.J. Effects of Deterioration Parameters on Storage of Maize. In Proceedings of the ASABE Annual International Meeting, Kansas City, MO, USA, 21–24 July 2013; p. 51. [Google Scholar]
- Castellari, C.C.; Cendoya, M.G.; Marcos Valle, F.J.; Barrera, V.; Pacin, A.M. Factores Extrínsecos e Intrínsecos Asociados a Poblaciones Fúngicas Micotoxigénicas de Granos de Maíz (Zea mays L.) Almacenados En Silos Bolsa En Argentina. Rev. Argent. Microbiol. 2015, 47, 350–359. [Google Scholar] [CrossRef]
- Garcia, L.P.; Savi, G.D.; Santos, K.; Scussel, V.M. Fumonisins and Fungi in Dry Soybeans (Glycine max L.) for Human Consumption. Food Addit. Contam. Part B Surveill. 2016, 9, 79–84. [Google Scholar] [CrossRef] [PubMed]
- Gomes, D.P.; Kronka, A.Z.; Barrozo, L.M.; Silva, R.P.D.; Souza, A.L.; Silva, B.M.S.e.; Panizzi, R.D.C. Efeito Da Colhedora, Velocidade e Ponto de Coleta Na Contaminação de Sementes de Soja Por Fungos. Rev. Bras. Sementes 2009, 31, 160–166. [Google Scholar] [CrossRef]
- Njobeh, P.B.; Dutton, M.F.; Koch, S.H.; Chuturgoon, A.; Stoev, S.; Seifert, K. Contamination with Storage Fungi of Human Food from Cameroon. Int. J. Food Microbiol. 2009, 135, 193–198. [Google Scholar] [CrossRef] [PubMed]
- Zelaya, M.J.; González, H.H.L.; Resnik, S.L.; Pacin, A.M. Mycobiota and Potential Mycotoxin Contamination of Soybean RR in Different Production Areas in Argentina. Int. Res. J. Plant Sci. 2013, 4, 133–143. [Google Scholar]
- Bullerman, L.B.; Bianchini, A. Good Food-Processing Techniques: Stability of Mycotoxins in Processed Maize-Based Foods. In Mycotoxin Reduction in Grain Chains; John Wiley & Sons: Hoboken, NJ, USA, 2014; pp. 89–100. [Google Scholar]
- Kumera, N.; Mohammed, A. Mycotoxin Occurrence in Grains and the Role of Postharvest Management as a Mitigation Strategies. A Review. Food Cont. 2017, 78, 412–425. [Google Scholar]
- Schollenberger, M.; Müller, H.M.; Rüfle, M.; Suchy, S.; Plank, S.; Drochner, W. Natural Occurrence of 16 Fusarium Toxins in Grains and Feedstuffs of Plant Origin from Germany. Mycopathologia 2006, 161, 43–52. [Google Scholar] [CrossRef]
- Waskiewicz, A. Natural Occurrence of Mycotoxins in Food. Encycl. Food Microbiol. 2014, 2, 880–886. [Google Scholar]
- Mishra, S.; Ansari, K.M.; Dwivedi, P.D.; Pandey, H.P.; Das, M. Occurrence of Deoxynivalenol in Cereals and Exposure Risk Assessment in Indian Population. Food Control 2013, 30, 549–555. [Google Scholar] [CrossRef]
- WHO. Safety Evaluation of Certain Mycotoxins in Food. In FAO Food and Nutrition Paper 74; WHO Food Additives Series 47; WHO: Genève, Switzerland, 2001; pp. 419–455. [Google Scholar]
- Rotter, B.A.; Prelusky, D.B.; Pestka, J.J. Invited Review: Toxicology of deoxynivalenol (vomitoxin). J. Toxicol. Environ. Health 1996, 48, 1–34. [Google Scholar] [CrossRef]
- International Agency for Research on Cancer. Monographs on the Evaluation of Carcinogenic Risk of Chemicals to Humanas: Some Naturally Occurring Substances: Food Ítems and Constituents, Heterocyclic Aromatic Amines and Mycotoxins. Hum. Papillomaviruses 1993, 56, 609. [Google Scholar]
- Amuzie, C.J.; Pestka, J.J. Suppression of Insulin-Like Growth Factor Acid-Labile Subunit Expression—A Novel Mechanism for Deoxynivalenol-Induced Growth Retardation. Toxicol. Sci. 2010, 3, 412–421. [Google Scholar]
- Ellis, W.O.; Smith, J.P.; Simpson, B.K.; Oldham, J.H.; Scott, P.M. Aflatoxins in Food: Occurrence, Biosynthesis, Effects on Organisms, Detection, and Methods of Control. Crit. Rev. Food Sci. Nutr. 1991, 30, 403–439. [Google Scholar] [CrossRef] [PubMed]
- Bennett, J.; Klich, M. Mycotoxins: Clinical Microbiology Reviews. ASM 2003, 16, 497–516. [Google Scholar]
- International Agency for Research on Cancer. Monographs on the Evaluation of Carcinogenic Risk of Chemicals to Humanas: Some Traditionally Herbal Medicines, Some Mycotoxins, Naphthalene and Styrene; WHO: Genève, Switzerland, 2002; Volume 82, p. 601. [Google Scholar]
- Arapcheska, M.; Jovanovska, V.; Jankuloski, Z.; Hajruali –Musliu, Z.; Uzunov, R. Imapct of Aflatoxins on Animal and Human Health. Int. J. Innov. Sci. Eng. Technol. 2015, 2, 156–161. [Google Scholar]
- Joint FAO/WHO Expert Committee on Food Additives. Safety Evaluation of Certain Food Additives and Contaminants; Joint FAO/WHO Expert Committee on Food Additives AFLA: Geneva, Switzerland, 1998. [Google Scholar]
- Bhat, R.; Reddy, K.R.N. Challenges and Issues Concerning Mycotoxins Contamination in Oil Seeds and Their Edible Oils: Updates from Last Decade. Food Chem. 2017, 215, 425–437. [Google Scholar] [CrossRef]
- Ghaemmaghami, S.S.; Modirsaneii, M.; Khosravi, A.R.; Razzaghi-Abyaneh, M. Study on Mycoflora of Poultry Feed Ingredients and Finished Feed in Iran. Iran J. Microbiol. 2016, 8, 47–54. [Google Scholar]
- Gutleb, A.C.; Caloni, F.; Giraud, F.; Cortinovis, C.; Pizzo, F.; Hoffmann, L.; Bohn, T.; Pasquali, M. Detection of Multiple Mycotoxin Occurrences in Soy Animal Feed by Traditional Mycological Identification Combined with Molecular Species Identification. Toxicol. Rep. 2015, 2, 275–279. [Google Scholar] [CrossRef][Green Version]
- Barros, G.; Gacía, D.; Oviedo, M.S.; Ramirez, M.L.; Torres, A.; Chulze, S. Influencia Del Almacenamiento Sobre La Micoflora de Soja Utilizada Para La Producción de Harina. In VI Congreso Latinoamericano de Micología; Asociacion Latinoamericana de Micologia: Mar del Plata, Argentina; Buenos Aires, Argentina, 2008. [Google Scholar]
- Boca, R.T.; Pacin, A.M.; González, H.H.L.; Resnik, S.L.; Souza, J.C. Soja y Mocotoxinas: Flora Fùngica—Variedades—Prácticas Agronómicas. Aceites Grasas 2003, Tomo XIII, 510–515. [Google Scholar]
- Broggi, L.E.; Pacin, A.M.; Gasparovie, A.; Sacchi, C.; Rothermel, A.; Gallay, A.; Resnik, S. Natural Occurrence of Aflatoxins, Deoxynivalenol, Fumonisins and Zearalenone in Maize from Entre Ríos Province, Argentina. Mycotoxin Res. 2007, 23, 59–64. [Google Scholar] [CrossRef]
- Garrido, C.E.; González, H.L.; Salas, M.P.; Resnik, S.L.; Pacin, A.M. Mycoflora and Mycotoxin Contamination of Roundup Ready Soybean Harvested in the Pampean Region, Argentina. Mycotoxin Res. 2013, 29, 147–157. [Google Scholar]
- Gimeno, A.; Martins, M.L. Micotoxinas y Micotoxicosis en Animales y Humanos, 3rd ed.; Special Nutrients, Inc.: Miami, FL, USA, 2011. [Google Scholar]
- ASAE Standard—S352.2; Moisture Measurement—Unground Grain and Seeds. ASAE: St. Joseph, MI, USA, 2003; p. 593.
- Atlas, R.M. Handbook of Microbiological Media, 3rd ed.; CRC Press: Boca Raton, FL, USA, 2004; ISBN 978-0-429-12903-2. [Google Scholar]
- Pitt, J.I.; Hocking, A.D. Fungi and Food Spoilage; Springer International Publishing: Berlin/Heidelberg, Germany, 2009; ISBN 978-0-387-92206-5. [Google Scholar]
- Nelson, P.E.; Toussoun, T.A.; Marasas, W.F.O. Fusarium Species. An Illustrated Manual of Identification; The Pennsylvania State University Press: University Park, PA, USA, 1983. [Google Scholar]
- Barbosa, T.S.; Pereyra, C.M.; Soleiro, C.A.; Dias, E.O.; Oliveira, A.A.; Keller, K.M.; Silva, P.P.O.; Cavaglieri, L.R.; Rosa, C.A.R. Mycobiota and Mycotoxins Present in Finished Fish Feeds from Farms in the Rio de Janeiro State, Brazil. Int. Aquat. Res. 2013, 5, 3. [Google Scholar] [CrossRef]
- Zelaya, M.J. Estudio de La Micoflora Contaminante Del Germoplasma de Soja En Argentina; Universidad de Buenos Aires: Buenos Aires, Argentina, 2006. [Google Scholar]
- Castañares, E.; Martínez, M.; Cristos, D.; Rojas, D.; Lara, B.; Stenglein, S.; Dinolfo, M.I. Fusarium Species and Mycotoxin Contamination in Maize in Buenos Aires Province, Argentina. Eur. J. Plant Pathol. 2019, 155, 1265–1275. [Google Scholar] [CrossRef]
- Calori-Domingues, M.A.; Iwahashi, P.M.R.; Ponce, G.H.; Gloria, E.M.d.; Dias, C.T.d.S.; Button, D.C.; De Camargo, A.C. Aflatoxin B1 and Zearalenone in Soybeans: Occurrence and Distribution in Whole and Defective Kernels. Food Addit. Contam. Part B Surveill. 2018, 11, 273–280. [Google Scholar] [CrossRef] [PubMed]
- Schothorst, R.; van Egmond, H.P. Report from SCOOP Task 3.2.10 “Collection of Occurrence Data of Fusarium Toxins in Food and Assessment of Dietary Intake by the Population of EU Member States” Subtask: Trichothecenes. Tox. Let. 2004, 153, 133–143. [Google Scholar] [CrossRef] [PubMed]
- R Core Team. R: A Language and Environment for Statistical Computing; R Core Team: Vienna, Austria, 2023; Available online: https://www.r-project.org/ (accessed on 21 April 2023).
- Kruskal, W.H.; Wallis, W.A. Use of Ranks in OneCriterion Variance Analysis. J. Am. Stat. Assoc. 1952, 47, 583–621. [Google Scholar] [CrossRef]
- Dunn, J.T. Multiple Comparisons Using Rank Sums. Technometrics 1964, 6, 241–252. [Google Scholar] [CrossRef]
- Egbuta, M.A.; Mwanza, M.; Phoku, J.Z.; Chilaka, C.A.; Dutton, M.F. Comparative Analysis of Mycotoxigenic Fungi and Mycotoxins Contaminating Soya Bean Seeds and Processed Soya Bean from Nigerian Markets. Adv. Microbiol. 2016, 06, 1130–1139. [Google Scholar] [CrossRef]
- Roigé, M.B.; Aranguren, S.M.; Riccio, M.B.; Pereyra, S.; Soraci, A.L.; Tapia, M.O. Mycobiota and Mycotoxins in Fermented Feed, Wheat Grains and Corn Grains in Southeastern Buenos Aires Province, Argentina. Rev. Iberoam. Micol. 2009, 26, 233–237. [Google Scholar] [CrossRef]
- Ochandio, D.; Bartosik, R.; Gastón, A.; Abalone, R.; Arias Barreto, A.; Yommi, A. Modelling Respiration Rate of Soybean Seeds (Glycine max (L.)) in Hermetic Storage. J. Stored Prod. Res. 2017, 74, 36–45. [Google Scholar] [CrossRef]
- Piotrowska, M.; Śliżewska, K.; Biernasiak, J. Chapter 8: Mycotoxins in Cereal and Soybean-Based Food and Feed. In Soybean—Pest Resistance; El-Shemy, H.A., Ed.; InTech: Rijeka, Croatia, 2013; pp. 185–230. ISBN 978-953-51-0978-5. [Google Scholar]
- Coradi, P.C.; De Lacerda Filho, A.F.; Paes Chaves, J.B.; De Castro Melo, E. Effects of the Feed Processing in the Reduction of the Microbiological Contamination on the Final Product. Rev. Bras. Prod. Agroindustriais 2013, 15, 81–92. [Google Scholar]
- Buerman, E.C.; Worobo, R.W.; Padilla-Zakour, O.I. High Pressure Processing of Spoilage Fungi as Affected by Water Activity in a Diluted Apple Juice Concentrate. Food Cont. 2019, 8, 106779. [Google Scholar] [CrossRef]
- Okelo, P.O.; Wagner, D.D.; Carr, L.E.; Wheaton, F.W.; Douglass, L.W.; Joseph, S.W. Optimization of Extrusion Conditions for Elimination of Mesophilic Bacteria during Thermal Processing of Animal Feed Mash. Anim. Feed Sci. Technol. 2006, 129, 116–137. [Google Scholar] [CrossRef]
- Zelaya, M.J.; González, H.L.; Resnik, S.L.; Martinez, M.J. Microflora Contaminante En Soja Cosechada En La Principal Zona de Producción de La República Argentina. In Proceedings of the X Congreso Argentino de Ciencia y Tecnología de Alimentos. Primer Simposio Internacional de Nuevas Tecnologías, Mar del Plata, Argentina, 18–20 May 2005; p. 318. [Google Scholar]
- Chiotta, M.L.; Fumero, M.V.; Cendoya, E.; Palazzini, J.M.; Alaniz-Zanon, M.S.; Ramirez, M.L.; Chulze, S.N. Toxigenic Fungal Species and Natural Occurrence of Mycotoxins in Crops Harvested in Argentina. Rev. Argent. Microbiol. 2020, 52, 339–347. [Google Scholar] [CrossRef] [PubMed]
- Del Pilar Monge, M.; Magnoli, C.E.; Chiacchiera, S.M. Survey of Aspergillus and Fusarium Species and Their Mycotoxins in Raw Materials and Poultry Feeds from Córdoba, Argentina. Mycotoxin Res. 2012, 28, 111–122. [Google Scholar] [CrossRef]
- CAA. Código Alimentario Argentino Capítulo II: Condiciones Generales de Las Fábricas y Comercios de Alimentos; CAA: Buenos Aires, Argentina, 2023; p. 78. [Google Scholar]
- Jay, J.M.; Loessner, M.J.; Golden, D.A.; García de Fernando Minguillón, G.D. Microbiología Moderna de Los Alimentos; Acribia: Zaragoza, España, 2009; ISBN 84-200-1125-8. [Google Scholar]
- Hong, T.D.; Ellis, R.H.; Moore, D. Development of a Model to Predict the Effect of Temperature and Moisture on Fungal Spore Longevity. Ann. Bot. 1997, 79, 121–128. [Google Scholar] [CrossRef]
- Dalcero, A.; Magnoli, C.; Luna, M.; Ancasi, G.; Reynoso, M.M.; Chiacchiera, S.; Miazzo, R.; Palacio, G. Mycoflora and Naturally Occurring Mycotoxins in Poultry Feeds in Argentina. Mycopathologia 1998, 141, 37–43. [Google Scholar] [CrossRef]
- Maciel, G.; de la Torre, D.A.; Cardoso, L.M.; Cendoya, M.G.; Wagner, J.R.; Bartosik, R.E. Determination of Safe Storage Moisture Content of Soybean Expeller by Means of Sorption Isotherms and Product Respiration. J. Stored Prod. Res. 2020, 86, 101567. [Google Scholar] [CrossRef]
- Zhu, S.; Riaz, M.N.; Lusas, E.W. Effect of Different Extrusion Temperatures and Moisture Content on Lipoxygenase Inactivation and Protein Solubility in Soybeans. J. Agric. Food Chem. 1996, 44, 3315–3318. [Google Scholar] [CrossRef]
- Pacin, A. ¿Existe UN Diagnóstico Sobre Micotoxinas en Soja en Argentina? In Proceedings of the Workshop Calidad de la Producción y Granos con Valor Agregado, Mercosoja, Rosario-Santa Fe, Argentina, 2006; pp. 285–287. [Google Scholar]
- Abia, W.A.; Warth, B.; Sulyok, M.; Krska, R.; Tchana, A.N.; Njobeh, P.B.; Dutton, M.F.; Moundipa, P.F. Determination of Multi-Mycotoxin Occurrence in Cereals, Nuts and Their Products in Cameroon by Liquid Chromatography Tandem Mass Spectrometry (LC-MS/MS). Food Control 2013, 31, 438–453. [Google Scholar] [CrossRef]
- Pereira, C.S.; Cunha, S.C.; Fernandes, J.O. Prevalent Mycotoxins in Animal Feed: Occurrence and Analytical Methods. Toxins 2019, 11, 290. [Google Scholar] [CrossRef]
- Oviedo, M.S.; Ramirez, M.L.; Barros, G.G.; Chulze, S.N. Influence of Water Activity and Temperature on Growth and Mycotoxin Production by Alternaria Alternata on Irradiated Soya Beans. Int. J. Food Microbiol. 2011, 149, 127–132. [Google Scholar] [CrossRef] [PubMed]
- D’Espósito, R.E.; Jimeno, M.A.; Metz, M.P.; Cardozo, G. Aislamiento Micotoxinas En Silos Bolsa Con Granos de Maíz y Soja. In Proceedings of the I Jornada Nacional de Agroalimentos y Sustentabilidad, Córdoba, Argentina, 7 June 2019; pp. 1–3. [Google Scholar]
- Joint FAO/WHO Expert Committee on Food Additives. Summary and Conclusions. Seventy-Second Meeting of the Joint FAO/WHO Expert Committee on Food Additives (JECFA/72/SC); WHO: Geneva, Switzerland, 2010; p. 16. [Google Scholar]
- Greco, M.; Pardo, A.; Pose, G. Mycotoxigenic Fungi and Natural Co-Occurrence of Mycotoxins in Rainbow Trout (Oncorhynchus Mykiss) Feeds. Toxins 2015, 7, 4595–4609. [Google Scholar] [CrossRef] [PubMed]
- Barros, G.; Alaniz Zanon, M.S.; Abod, A.; Oviedo, M.S.; Ramirez, M.L.; Reynoso, M.M.; Torres, A.; Chulze, S. Natural Deoxynivalenol Occurrence and Genotype and Chemotype Determination of a Field Population of the Fusarium Graminearum Complex Associated with Soybean in Argentina. Food Addit. Contam. Part A Chem. Anal. Control. Expo. Risk Assess. 2012, 29, 293–303. [Google Scholar] [CrossRef] [PubMed]
- Ahammed, S.K.; Anandam, R.J.; Prasad Babu, G.; Munikrishnaiah, M.; Gopal, K. Studies on Seed Mycroflora of Soybean and Its Effect on Seed and Seedling Quality Characters. Legume Res. 2006, 29, 186–190. [Google Scholar]
- EFSA. Aflatoxins (Sum of B1, B2, G1, G2) in Cereals and Cereal-derived Food Products; EFSA: Parma, Italy, 2013; p. 11. [Google Scholar]
- Vaamonde, G.; Degrossi, C.; Comerio, R.; Fernandez Pinto, Y.V. Provincia de cordoba (argentina): Caracteristicas diferenciales y capacidad aflatoxicogenicA. Bol. Soc. Argent. Bot. 1995, 30, 191–198. [Google Scholar]
- Abarca, M.L.; Bragulat, M.R.; Castella, G.; Cabanes, F.J. Mycoflora and Aflatoxin-Producing Strains in Animal Mixed Feeds; Elsevier: Amsterdam, The Netherlands, 1994; Volume 57, pp. 256–258. [Google Scholar]
- Gourama, H.; Bullerman, L.B. Aspergillus Flavus and Aspergillus Parasiticus: Aflatoxigenic Fungi of Concern in Foods and Feeds T: A Review. J. Food Prot. 1995, 58, 1395–1404. [Google Scholar]
- Ricca, A.P. Gestion de La Inocuidad En Los Granos Para Potenciar Su Valor Agregado. In Integración Asociativa del Campo a la Góndola; Ediciones, I., Ed.; 1° Congreso de Valor Agregado en Origen; Manfredi: Códoba, Argentina, 2012; pp. 225–229. [Google Scholar]
- Ehling, G.; Cockburn, A.; Snowdon, P.; Buschhaus, H. The Significance of the Fusarium Toxin Deoxynivalenol (DON) for Human and Animal Health. Cereal Res. Commun. 1997, 25, 443–447. [Google Scholar]
- Hazel, C.M.; Patel, S. Influence of Processing on Trichothecene Levels. Toxicol. Lett. 2004, 153, 51–59. [Google Scholar] [CrossRef]
- Lori, G.A.; Rizzo, I. Deoxinivalenol. In Micotoxinas en Alimentos; Editorial Díaz de Santos, S.A.: Madrid, Spain, 2007; pp. 269–292. ISBN 978-84-9969-962-2. [Google Scholar]
- Jalili, M. A Review on Aflatoxins Reduction in Food. Iran. J. Health Saf. Environ. 2015, 3, 445–459. [Google Scholar]
- Cazzaniga, D.; Basílico, J.C.; González, R.J.; Torres, R.L.; De Greef, D.M. Mycotoxins Inactivation by Extrusion Cooking of Corn Flour. Lett. Appl. Microbiol. 2001, 33, 144–147. [Google Scholar] [CrossRef]
- Binder, E.M.; Tan, L.M.; Chin, L.J.; Handl, J.; Richard, J. Worldwide Occurrence of Mycotoxins in Commodities, Feeds and Feed Ingredients. Anim. Feed Sci. Technol. 2007, 137, 265–282. [Google Scholar] [CrossRef]
- Regulation EC. Regulation (EC) N° 1881/2006. Setting Maximum Levels for Certain Contaminants in Foodstuffs; EU: Brussels, Belgium, 2006; Volume L 364. [Google Scholar]
- FDA. Guidance for Industry: Action Levels for Poisonous or Deleterious Substances in Human Food and Animal; FDA: Silver Spring, MD, USA, 2000. [Google Scholar]
- Abadia, B.; Bartosik, R. Manual de Buenas Prácticas En Poscosecha de Granos: Hacia El Agregado de Valor En Origen de La Producción Primaria; Bernadette, A., Bartosik, R., Eds.; Ediciones INTA: Buenos Aires, Argentina, 2013; ISBN 978-987-679-264-6. [Google Scholar]
- Lusas, E.W. Soybean Processing and Utilization. In Soybeans: Improvement, Production, and Uses; American Society of Agronomy, Crop Science Society of America, Soil Science Society of America: Madison, WI, USA, 2004; Volume 16, pp. 949–1045. [Google Scholar]
- Magan, N.; Aldred, D.; Baxter, E.S. Good Postharvest Storage Practices for Wheat Grain. In Mycotoxin Reduction in Grain Chains; John Wiley & Sons: Hoboken, NJ, USA, 2014. [Google Scholar]
- Toomer, O.T.; Oviedo, E.O.; Ali, M.; Patino, D.; Joseph, M.; Frinsko, M.; Vu, T.; Maharjan, P.; Fallen, B.; Mian, R. Current Agronomic Practices, Harvest & Post-Harvest Processing of Soybeans (Glycine max)—A Review. Agronomy 2023, 13, 427. [Google Scholar] [CrossRef]

| Facility ID | Alternaria spp. | Aspergillus spp. | Fusarium spp. | Mucoraceae (family) | Penicillium spp. | Total Yeasts | Other |
|---|---|---|---|---|---|---|---|
| Facility 1 | 0.5 | 0.5 | 0 | 77.0 | 7.8 | 3.6 | 10.6 |
| Facility 2 | 0 | 6.2 | 46.0 | 0.9 | 4.5 | 37.4 | 5.0 |
| Facility 3 | 0 | 0 | 0 | 0 | 0 | 100 | 0 |
| Facility 4 | 0 | 0 | 0 | 2.6 | 7.3 | 52.3 | 37.7 |
| Facility 5 | 0 | 68.8 | 0 | 1.3 | 29.0 | 0.5 | 0.3 |
| Facility 6 | 0 | 0 | 0 | 0 | 0 | 52.6 | 47.4 |
| Facility 7 | 0.9 | 2.2 | 0 | 1.9 | 1.9 | 0.5 | 92.5 |
| Facility 8 | 0.3 | 0.3 | 0 | 79.0 | 2.1 | 16.2 | 2.1 |
| Facility 9 | 0 | 18.2 | 0 | 27.3 | 36.4 | 9.1 | 9.1 |
| Facility 10 | 0 | 0 | 0 | 0 | 30.0 | 55.0 | 15.0 |
| Facility 11 | 0 | 0 | 0 | 1.6 | 93.8 | 2.7 | 2.0 |
| Facility ID | Repetition | DON | AFs | |||
|---|---|---|---|---|---|---|
| B1 | B2 | G1 | G2 | |||
| LOD (μg kg−1) | 3 | 0.2 | 0.1 | 0.2 | 0.1 | |
| LOQ (μg kg−1) | 10 | 0.3 | 0.2 | 0.3 | 0.2 | |
| Facility 1 | 1 | nd | <LOQ | <LOQ | 0.9 | 1.3 |
| 2 | nd | nd | nd | 0.5 | 0.6 | |
| 3 | nd | nd | nd | nd | nd | |
| 4 | nd | nd | nd | 0.3 | <LOQ | |
| 5 | nd | <LOQ | <LOQ | 1.0 | 0.6 | |
| Facility 2 | 1 | nd | nd | nd | 0.7 | 0.9 |
| 2 | nd | <LOQ | <LOQ | 0.6 | 0.6 | |
| 3 | nd | nd | nd | 0.5 | 0.6 | |
| Facility 3 | 1 | nd | <LOQ | <LOQ | nd | nd |
| 2 | nd | nd | nd | nd | nd | |
| 3 | nd | <LOQ | <LOQ | nd | 0.3 | |
| Facility 5 | 1 | nd | 0.3 | nd | nd | nd |
| 2 | nd | 0.3 | nd | nd | nd | |
| 3 | nd | <LOQ | <LOQ | nd | nd | |
| 4 | nd | <LOQ | <LOQ | 0.4 | 0.6 | |
| 5 | nd | nd | nd | nd | nd | |
| 6 | nd | <LOQ | <LOQ | nd | nd | |
| 7 | nd | <LOQ | <LOQ | nd | nd | |
| 8 | nd | nd | nd | nd | nd | |
| Facility 7 | 1 | nd | <LOQ | <LOQ | 0.3 | 0.5 |
| 2 | nd | <LOQ | <LOQ | 0.7 | 0.9 | |
| 3 | nd | <LOQ | <LOQ | 0.7 | 1.1 | |
| Facility 8 | 1 | 1038.4 | 159.0 | nd | nd | nd |
| 2 | 2385.2 | 256.5 | nd | nd | nd | |
| 3 | 741.6 | 127.0 | nd | nd | nd | |
| Facility 9 | 1 | nd | <LOQ | <LOQ | 0.6 | 0.5 |
| 2 | nd | <LOQ | <LOQ | 0.7 | 0.6 | |
| 3 | nd | <LOQ | <LOQ | <LOQ | <LOQ | |
| Facility 10 | 1 | nd | nd | nd | nd | nd |
| 2 | nd | <LOQ | <LOQ | 3.6 | 1.7 | |
| 3 | nd | nd | nd | nd | nd | |
| Facility 11 | 1 | 529.2 | 378.0 | nd | nd | nd |
| 2 | 1573.8 | 231.8 | nd | nd | nd | |
| 3 | 706.7 | 180.4 | nd | nd | nd | |
| 4 | 514.6 | 122.0 | nd | nd | nd | |
| Minimum (μg kg−1) | 1.50 | 0.10 | 0.05 | 0.10 | 0.05 | |
| 1st Quartil (μg kg−1) | 1.50 | 0.10 | 0.05 | 0.10 | 0.05 | |
| Median (μg kg−1) | 1.50 | 0.15 | 0.05 | 0.10 | 0.05 | |
| Mean (μg kg−1) | 215.19 | 41.68 | 0.07 | 0.39 | 0.34 | |
| 3rd Quartil (μg kg−1) | 1.50 | 0.21 | 0.10 | 0.57 | 0.60 | |
| Maximum (μg kg−1) | 2385.20 | 378.00 | 0.10 | 3.55 | 1.74 | |
| Positives * | 7 | 9 | 0 | 14 | 14 | |
| Percentage of positives (%) | 20.0 | 25.7 | 0 | 40.0 | 40.0 | |
Disclaimer/Publisher’s Note: The statements, opinions and data contained in all publications are solely those of the individual author(s) and contributor(s) and not of MDPI and/or the editor(s). MDPI and/or the editor(s) disclaim responsibility for any injury to people or property resulting from any ideas, methods, instructions or products referred to in the content. |
© 2025 by the authors. Licensee MDPI, Basel, Switzerland. This article is an open access article distributed under the terms and conditions of the Creative Commons Attribution (CC BY) license (https://creativecommons.org/licenses/by/4.0/).
Share and Cite
Maciel, G.; Castellari, C.C.; Cardoso, L.M.; Abadía, M.B.; Busato, P.; Bartosik, R.E. Fungal Biota and Mycotoxins Contamination in Soybean Expeller. Agronomy 2025, 15, 807. https://doi.org/10.3390/agronomy15040807
Maciel G, Castellari CC, Cardoso LM, Abadía MB, Busato P, Bartosik RE. Fungal Biota and Mycotoxins Contamination in Soybean Expeller. Agronomy. 2025; 15(4):807. https://doi.org/10.3390/agronomy15040807
Chicago/Turabian StyleMaciel, Gisele, Claudia Carla Castellari, Leandro Marcelo Cardoso, María Bernadette Abadía, Patrizia Busato, and Ricardo Enrique Bartosik. 2025. "Fungal Biota and Mycotoxins Contamination in Soybean Expeller" Agronomy 15, no. 4: 807. https://doi.org/10.3390/agronomy15040807
APA StyleMaciel, G., Castellari, C. C., Cardoso, L. M., Abadía, M. B., Busato, P., & Bartosik, R. E. (2025). Fungal Biota and Mycotoxins Contamination in Soybean Expeller. Agronomy, 15(4), 807. https://doi.org/10.3390/agronomy15040807

